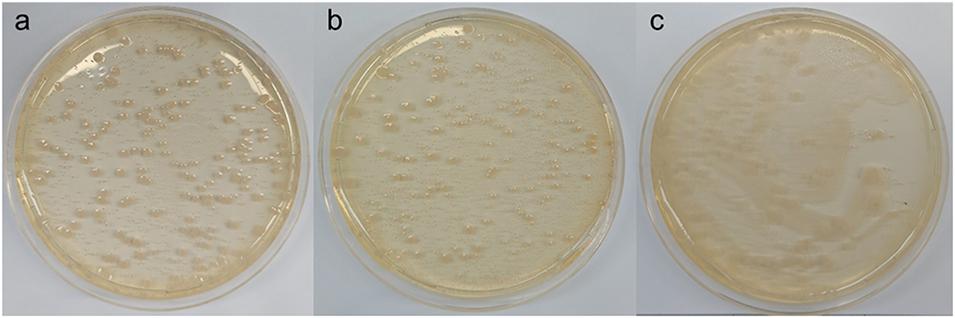

磷酸盐过量输入导致水体富营养化,2100年预计恶化120%-390%,对全球变暖贡献率达38%-53%。传统处理方法如化学沉淀、生物降解,因处理精度有限、产生大量污泥,已难以满足日益严格的排放法规要求。
全氟和多氟烷基物质(PFAS)广泛应用于消防泡沫、工业涂料、纺织品等领域,其化学结构稳定、难以降解,且具有强生物累积性和潜在毒性,对生态系统和人体健康构成严重威胁。现有处理技术如电化学降解、高级氧化等,不仅能耗高、工艺复杂,还易产生有毒副产物,同时造成资源浪费。


鉴于此,上海交通大学任龙飞副研究员团队创新性提出一种“废物资源化”策略,利用液滴微流控辅助化学交联技术,将废弃PFAS接枝到单分散微球上,成功制备出无毒高效的磷酸盐吸附剂(PFAS-FMM)。该吸附剂通过单一位点接枝提升氨基利用率,同步实现PFAS污染治理与磷酸盐高效去除,为解决双水体污染难题提供了可持续方案。相关研究以“Droplet-Microfluidic-Assisted Conversion of Per- and Polyfluoroalkyl Substances to Nontoxic Microspheres for Enhanced Phosphate Capture”为题目,发表于期刊《ACS Applied Materials & Interfaces》。
本文要点:
1、该研究提出一种可持续方案,借助液滴微流控辅助化学交联技术,将具有污染性的全氟和多氟烷基物质(PFAS)接枝到单分散微球上,成功制备出稳定、高效且环保的磷吸附剂(PFAS-FMM)。
2、研究先以聚乙烯亚胺(PEI)为模型功能单体验证了微球制备策略的可行性,随后系统优化了三相流速、接枝单体浓度等合成参数。所制得的PFAS-FMM具有均匀的球形形貌和明确的核壳结构,通过单一位点接枝方式,使氨基利用率提升4.29倍,显著增强了对磷酸盐的静电引力和氢键作用。
3、性能测试表明,PFAS-FMM对磷酸盐(50 mg P/L)的最大吸附容量达252.5 mg/g PFAS,120分钟内即可达到吸附平衡,且对多种竞争阴离子具有耐受性,经过5次吸附-解吸循环后仍能保持85%以上的吸附容量。同时,微球封装有效抑制了PFAS的泄漏,降低了其毒性,大肠杆菌生长抑制实验和氟释放实验均证实了其环境安全性。
4、整体可持续性足迹(OSF)评估得分为87.5%,在环境友好性、废物利用、可扩展性和可重复使用性等方面表现优异。该研究为功能材料合成提供了新思路,实现了PFAS污染治理与磷酸盐去除的双重目标,为水生生态系统修复提供了潜在解决方案。

该研究将PFAS转化为吸附剂的策略,相比传统PFAS处理技术有哪些创新?
①理念创新:摒弃传统“破坏性处理”思路,采用“废物资源化”策略,将有毒污染物PFAS转化为高价值的磷酸盐吸附剂,实现污染物的二次利用;
②技术创新:利用液滴微流控技术实现吸附剂的精准制备,解决PFAS难以稳定固定的问题,同时提升活性位点利用率;
③效益创新:同步解决PFAS污染和水体富营养化两大难题,OSF可持续性评分达87.5%,在环境友好性、可扩展性上优于传统吸附剂,具有更广泛的应用前景。

图1 液滴微流控与化学交联法制备 PEI-FMM 和 PFAS-FMM 的示意图。

图2 三相流速对 PEI-FMM 磷酸盐吸附容量的影响(a);不同戊二醛(GA)浓度(b)和聚乙烯亚胺(PEI)浓度(c,分子量 25000 g/mol)下制备的 PEI-FMM 光学显微镜图像;三相流速对 PFAS-FMM 磷酸盐吸附容量的影响(d);不同全氟和多氟烷基物质(PFAS)浓度下制备的 PFAS-FMM 光学显微镜图像(e)。

图3 未改性微球(UM)(a)、PEI-FMM(b)和 PFAS-FMM(c)的扫描电子显微镜(SEM)图像;PEI-FMM(d)和 PFAS-FMM(e)的能量色散光谱(EDS) 图;UM、PEI-FMM 和 PFAS-FMM 的傅里叶变换红外光谱(FT-IR)(f)和 X 射线光电子能谱(XPS)(g);PEI(h)/PFAS(i)与微球的交联机理示意图。

图4 pH 值对 PEI-GA 和 PEI-FMM 吸附磷酸盐的影响(a);PEI-GA 和 PEI-FMM 对磷酸盐的吸附等温线及模型拟合结果(b);PEI-FMM 中氨基利用率提升的示意图(c)。

图5 pH 值对 PFAS-FMM 吸附磷酸盐的影响(a);PFAS-FMM 对磷酸盐的吸附等温线(b)和动力学曲线(c)及模型拟合结果;磷酸盐浓度(d)和竞争阴离子(e)对 PFAS-FMM 吸附磷酸盐的影响;PFAS-FMM 在 5 次循环中的重复使用性能(f)。

图6 PFAS-FMM 吸附磷酸盐前后的 FT-IR 光谱(a)和 XPS 光谱(b);PFAS-FMM 吸附磷酸盐前后的高分辨率 N 1s XPS 光谱(c);磷酸盐吸附前后溶液 pH 值变化(d);PFAS-FMM 吸附磷酸盐的机理示意图(e)。
图7 大肠杆菌在纯水(a)、PFAS-FMM(b)和游离 PFAS(c)培养条件下形成的菌落图像。

图8 PFAS-FMM(a)、PEI-FMM(b)和 PEI-GA(c)的整体可持续性足迹(OSF)分析;基于 8 项指标的 PFAS-FMM(d)、PEI-FMM(e)和 PEI-GA(f)综合评分。
论文链接:https://doi.org/10.1021/acsami.5c21690
(本文仅供参考学习及传递微流控研究成果,版权归原作者所有,如侵犯权益,请联系删除)






